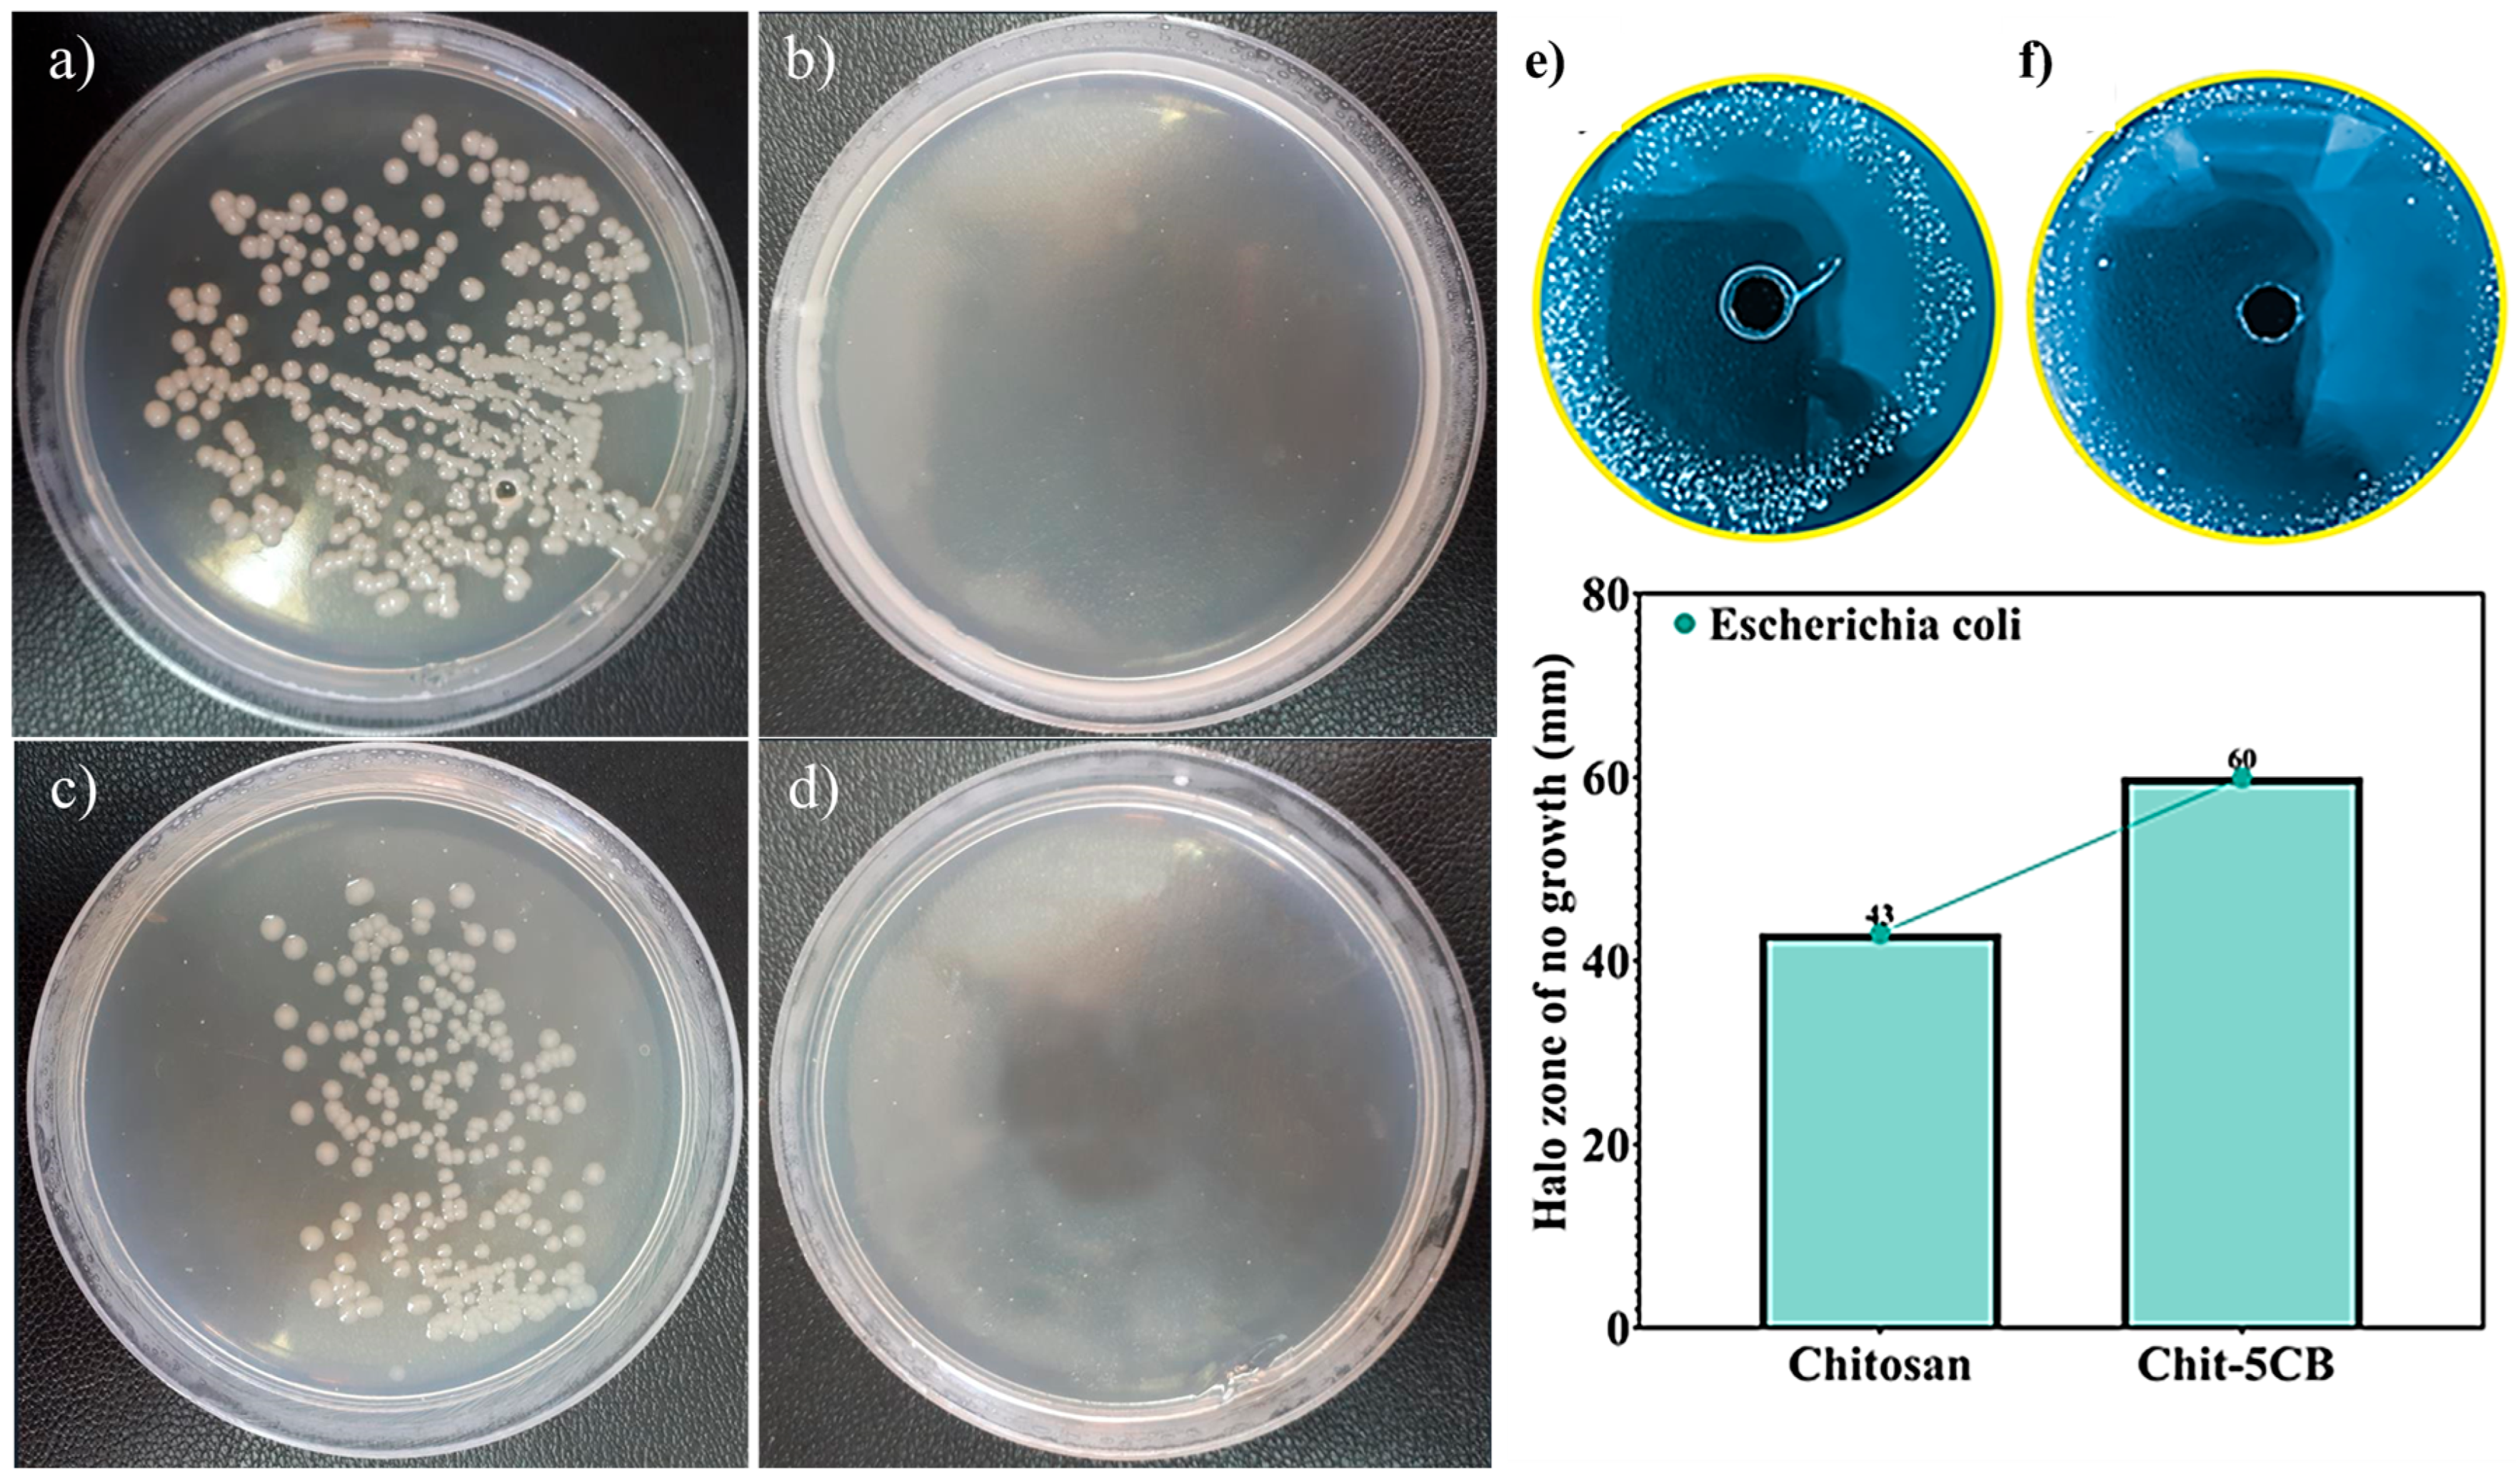
Crystals 15 00549 g007

Electrophoretic Co-Deposition of Chitosan and Cu-Doped Bioactive Glass 45S5 Composite Coatings on AISI 316L Stainless Steel Substrate for Biomedical Applications
Abstract
1. Introduction
2. Materials and Methods
2.1. Materials
2.2. Sample Preparation Methods
2.3. Characterizations
2.4. Antibacterial Evaluations
2.5. In Vitro and Biocompatibility Studies
3. Results and Discussion
3.1. Topography of Coating Layers
3.2. Wettability Evaluation of Coating Layers
3.3. XRD Results
3.4. Adhesion Test
3.5. SEM/EDS Analysis of Chit-5CB Sample (The Optimum Sample)
3.6. Antibacterial Assessments
3.7. MTT Test
3.8. Bioactivity Analysis
4. Conclusions
Author Contributions
Funding
Data Availability Statement
Conflicts of Interest
References
- Deng, R.; Wei, R.; Zhang, Y.; Zhao, C.; Liang, J.; Bai, Q.; Li, H.; Ouyang, C.; He, Q.; Liu, S.; et al. Investigation of variable-temperature wear characteristics of austenitic stainless steel coatings fabricated via laser energy deposition. Wear 2025, 572–573, 205993. [Google Scholar] [CrossRef]
- Xu, K.; Xiao, X.; Wang, L.; Lou, M.; Wang, F.; Li, C.; Ren, H.; Wang, X.; Chang, K. Data-Driven Materials Research and Development for Functional Coatings. Adv. Sci. 2024, 11, 2405262. [Google Scholar] [CrossRef]
- Heidari Laybidi, F.; Bahrami, A. Antibacterial properties of ZnO-containing bioactive glass coatings for biomedical applications. Mater. Lett. 2024, 365, 136433. [Google Scholar] [CrossRef]
- Wang, S.; Zhao, X.; Hsu, Y.; He, Y.; Wang, F.; Yang, F.; Yan, F.; Xia, D.; Liu, Y. Surface modification of titanium implants with Mg-containing coatings to promote osseointegration. Acta Biomater. 2023, 169, 19–44. [Google Scholar] [CrossRef] [PubMed]
- Amirtharaj Mosas, K.K.; Chandrasekar, A.R.; Dasan, A.; Pakseresht, A.; Galusek, D. Recent Advancements in Materials and Coatings for Biomedical Implants. Gels 2022, 8, 323. [Google Scholar] [CrossRef] [PubMed]
- González-Reyna, M.A.; Espinosa-Medina, M.A.; Esparza, R.; Hernández-Martinez, A.R.; Maya-Cornejo, J.; Estévez, M. Anticorrosive Effect of the Size of Silica Nanoparticles on PMMA-Based Hybrid Coatings. J. Mater. Eng. Perform. 2021, 30, 1054–1065. [Google Scholar] [CrossRef]
- Taveri, G.; Hanzel, O.; Sedláček, J.; Toušek, J.; Neščaková, Z.; Michálek, M.; Dlouhý, I.; Hnatko, M. Consolidation of Bioglass® 45S5 suspension through cold isostatic pressing. Ceram. Int. 2021, 47, 4090–4096. [Google Scholar] [CrossRef]
- Rajabinezhad, M.; Bahrami, A.; Abbasi, M.S.; Karampoor, M.R. A promising multi-component, multi-functional, drug-releasing Cu-doped Fe3O4/bioactive glass/Chitosan coating, applied on stainless steel substrate for biomedical applications. Int. J. Biol. Macromol. 2025, 310, 143296. [Google Scholar] [CrossRef]
- Vafa, E.; Bazargan-Lari, R.; Bahrololoom, M.E. Electrophoretic deposition of polyvinyl alcohol/natural chitosan/bioactive glass composite coatings on 316L stainless steel for biomedical application. Prog. Org. Coat. 2021, 151, 106059. [Google Scholar] [CrossRef]
- Wang, M.; Zheng, Y.; Yin, C.; Dai, S.; Fan, X.; Jiang, Y.; Liu, X.; Fang, J.; Yi, B.; Zhou, Q.; et al. Recent Progress in antibacterial hydrogel coatings for targeting biofilm to prevent orthopedic implant-associated infections. Front. Microbiol. 2023, 14, 1343202. [Google Scholar] [CrossRef]
- Daly, A.C.; Freeman, F.E.; Gonzalez-Fernandez, T.; Critchley, S.E.; Nulty, J.; Kelly, D.J. 3D Bioprinting for Cartilage and Osteochondral Tissue Engineering. Adv. Heal. Mater. 2017, 6, 1700298. [Google Scholar] [CrossRef] [PubMed]
- Fernandes, H.R.; Gaddam, A.; Rebelo, A.; Brazete, D.; Stan, G.E.; Ferreira, J.M.F. Bioactive Glasses and Glass-Ceramics for Healthcare Applications in Bone Regeneration and Tissue Engineering. Materials 2018, 11, 2530. [Google Scholar] [CrossRef] [PubMed]
- Brunello, G.; Elsayed, H.; Biasetto, L. Bioactive Glass and Silicate-Based Ceramic Coatings on Metallic Implants: Open Challenge or Outdated Topic? Materials 2019, 12, 2929. [Google Scholar] [CrossRef]
- Agnes, C.J.; Karoichan, A.; Tabrizian, M. The Diamond Concept Enigma: Recent Trends of Its Implementation in Cross-linked Chitosan-Based Scaffolds for Bone Tissue Engineering. ACS Appl. Bio Mater. 2023, 6, 2515–2545. [Google Scholar] [CrossRef]
- Bhaskar, P.; Kumar, R.; Maurya, Y.; Ravinder, R.; Allu, A.R.; Das, S.; Gosvami, N.N.; Youngman, R.E.; Bødker, M.S.; Mascaraque, N.; et al. Cooling rate effects on the structure of 45S5 bioglass: Insights from experiments and simulations. J. Non-Cryst. Solids 2020, 534, 119952. [Google Scholar] [CrossRef]
- Pádua, A.S.; Gavinho, S.R.; Vieira, T.; Hammami, I.; Silva, J.C.; Borges, J.P.; Graça, M.P.F. In Vitro Characterization of Doped Bioglass 45S5/HAp Coatings Obtained by CoBlastTM Deposition. Coatings 2023, 13, 1775. [Google Scholar] [CrossRef]
- Abbasi, M.S.; Yousef Saber, F.; Bahrami, A.; Torkian, S.; Hosseini-Abari, A. Towards an anticancer bioactive glass-Fe3O4/Pectin/Pectic oligosaccharide coatings for biomedical applications. Surf. Interfaces 2024, 45, 103874. [Google Scholar] [CrossRef]
- Rajabinezhad, M.; Abbasi, M.S.; Laybidi, F.H.; SharifianJazi, M.; Khodaei, M.; Bahrami, A. Structural, mechanical and biomedical properties of 3D-printed Cu-doped Fe3O4/58S bioactive glass/polycaprolactone composite scaffold for bone tissue regeneration. Bioprinting 2025, 47, e00400. [Google Scholar] [CrossRef]
- Heidarpour, S.; Heidari Laybidi, F.; Bahrami, A.; Abbasi, M.S.; Hosseini-Abari, A.; Ashrafian, B. Antibacterial properties of anthracite/CuO nanocomposites. Mater. Lett. 2023, 352, 135139. [Google Scholar] [CrossRef]
- Koné, K.E.; Bouich, A.; Soucase, B.M.; Soro, D. Manufacture of different oxides with high uniformity for copper zinc tin sulfide (CZTS) based solar cells. J. Mol. Graph. Model. 2023, 121, 108448. [Google Scholar] [CrossRef]
- Vasiliev, G.; Kubo, A.-L.; Vija, H.; Kahru, A.; Bondar, D.; Karpichev, Y.; Bondarenko, O. Synergistic antibacterial effect of copper and silver nanoparticles and their mechanism of action. Sci. Rep. 2023, 13, 9202. [Google Scholar] [CrossRef] [PubMed]
- Ulloa-Ogaz, A.L.; Piñón-Castillo, H.A.; Muñoz-Castellanos, L.N.; Athie-García, M.S.; Ballinas-Casarrubias, M.D.L.; Murillo-Ramirez, J.G.; Flores-Ongay, L.Á.; Duran, R.; Orrantia-Borunda, E. Oxidative damage to Pseudomonas aeruginosa ATCC 27833 and Staphylococcus aureus ATCC 24213 induced by CuO-NPs. Environ. Sci. Pollut. Res. 2017, 24, 22048–22060. [Google Scholar] [CrossRef]
- Sathiyavimal, S.; Vasantharaj, S.; Kaliannan, T.; Garalleh, H.A.L.; Garaleh, M.; Brindhadevi, K.; Chi, N.T.L.; Sharma, A.; Pugazhendhi, A. Bio-functionalized copper oxide/chitosan nanocomposite using Sida cordifolia and their efficient properties of antibacterial, anticancer activity against on breast and lung cancer cell lines. Environ. Res. 2023, 218, 114986. [Google Scholar] [CrossRef]
- Sathiyavimal, S.; FDurán-Lara, E.; Vasantharaj, S.; Saravanan, M.; Sabour, A.; Alshiekheid, M.; Lan Chi, N.T.; Brindhadevi, K.; Pugazhendhi, A. Green synthesis of copper oxide nanoparticles using Abutilon indicum leaves extract and their evaluation of antibacterial, anticancer in human A549 lung and MDA-MB-231 breast cancer cells. Food Chem. Toxicol. 2022, 168, 113330. [Google Scholar] [CrossRef] [PubMed]
- Verma, N.; Kumar, N. Synthesis and Biomedical Applications of Copper Oxide Nanoparticles: An Expanding Horizon. ACS Biomater. Sci. Eng. 2019, 5, 1170–1188. [Google Scholar] [CrossRef]
- Baratipour, S.; Bahrami, A.; Eslami, A.; Alihosseini, F. Toward Antibacterial Anodized Surfaces in Ti6Al4V Alloy Using Silver Nanoparticles and Pectin Coating for Biomedical Applications. J. Mater. Eng. Perform. 2024. [Google Scholar] [CrossRef]
- Liu, H.; Yu, Z.; Liu, L.; Dong, S. Cell Wall Binding Strategies Based on Cu3SbS3 Nanoparticles for Selective Bacterial Elimination and Promotion of Infected Wound Healing. ACS Appl. Mater. Interfaces 2024, 16, 33038–33052. [Google Scholar] [CrossRef]
- Miguel, S.P.; Moreira, A.F.; Correia, I.J. Chitosan based-asymmetric membranes for wound healing: A review. Int. J. Biol. Macromol. 2019, 127, 460–475. [Google Scholar] [CrossRef]
- Rajamma, R.; Gopalakrishnan Nair, S.; Abdul Khadar, F.; Baskaran, B. Antibacterial and anticancer activity of biosynthesised CuO nanoparticles. IET Nanobiotechnol. 2020, 14, 833–838. [Google Scholar] [CrossRef]
- Avcu, E.; Baştan, F.E.; Abdullah, H.Z.; Rehman, M.A.U.; Avcu, Y.Y.; Boccaccini, A.R. Electrophoretic deposition of chitosan-based composite coatings for biomedical applications: A review. Prog. Mater. Sci. 2019, 103, 69–108. [Google Scholar] [CrossRef]
- Wang, W.; Xue, C.; Mao, X. Chitosan: Structural modification, biological activity and application. Int. J. Biol. Macromol. 2020, 164, 4532–4546. [Google Scholar] [CrossRef] [PubMed]
- Burgos-Díaz, C.; Opazo-Navarrete, M.; Palacios, J.L.; Barahona, T.; Mosi-Roa, Y.; Anguita-Barrales, F.; Bustamante, M. Synthesis of New Chitosan from an Endemic Chilean Crayfish Exoskeleton (Parastacus pugnax): Physicochemical and Biological Properties. Polymers 2021, 13, 2304. [Google Scholar] [CrossRef] [PubMed]
- Zhang, B.; Lan, W.; Xie, J. Chemical modifications in the structure of marine polysaccharide as serviceable food processing and preservation assistant: A review. Int. J. Biol. Macromol. 2022, 223, 1539–1555. [Google Scholar] [CrossRef] [PubMed]
- Khubiev, O.M.; Egorov, A.R.; Kirichuk, A.A.; Khrustalev, V.N.; Tskhovrebov, A.G.; Kritchenkov, A.S. Chitosan-Based Antibacterial Films for Biomedical and Food Applications. Int. J. Mol. Sci. 2023, 24, 10738. [Google Scholar] [CrossRef] [PubMed]
- Muxika, A.; Etxabide, A.; Uranga, J.; Guerrero, P.; de la Caba, K. Chitosan as a bioactive polymer: Processing, properties and applications. Int. J. Biol. Macromol. 2017, 105, 1358–1368. [Google Scholar] [CrossRef]
- Laybidi, F.H.; Bahrami, A.; Abbasi, M.S.; Mokhtari, M.A.; Dehkordi, M.J.; Karampoor, M.R. The promising application of pectin/ɛ-polylysine as coating material on anodized titanium surfaces for orthopedic implants: Preparation, characterization and biomedical properties. Colloids Surf. A Physicochem. Eng. Asp. 2025, 704, 135517. [Google Scholar] [CrossRef]
- Oliveira, J.A.M.; de Santana, R.A.C.; Wanderley Neto Ade, O. Electrophoretic deposition and characterization of chitosan-molybdenum composite coatings. Carbohydr. Polym. 2021, 255, 117382. [Google Scholar] [CrossRef]
- Maciąg, F.; Moskalewicz, T.; Kowalski, K.; Łukaszczyk, A.; Hadzhieva, Z.; Boccaccini, A.R. The Effect of Electrophoretic Deposition Parameters on the Microstructure and Adhesion of Zein Coatings to Titanium Substrates. Materials 2021, 14, 312. [Google Scholar] [CrossRef]
- Hu, S.; Li, W.; Finklea, H.; Liu, X. A review of electrophoretic deposition of metal oxides and its application in solid oxide fuel cells. Adv. Colloid Interface Sci. 2020, 276, 102102. [Google Scholar] [CrossRef]
- Manzur, J.; Akhtar, M.; Aizaz, A.; Ahmad, K.; Yasir, M.; Minhas, B.Z.; Avcu, E.; Ur Rehman, M.A. Electrophoretic Deposition, Microstructure, and Selected Properties of Poly(lactic-co-glycolic) Acid-Based Antibacterial Coatings on Mg Substrate. ACS Omega 2023, 8, 18074–18089. [Google Scholar] [CrossRef]
- ASTM D3359-23; Standard Test Methods for Rating Adhesion by Tape Test. ASTM: West Conshohocken, PA, USA, 2023.
- Zhang, E.; Zhao, X.; Hu, J.; Wang, R.; Fu, S.; Qin, G. Antibacterial metals and alloys for potential biomedical implants. Bioact. Mater. 2021, 6, 2569–2612. [Google Scholar] [CrossRef]
- Deen, I.; Selopal, G.S.; Wang, Z.M.; Rosei, F. Electrophoretic deposition of collagen/chitosan films with copper-doped phosphate glasses for orthopaedic implants. J. Colloid Interface Sci. 2022, 607, 869–880. [Google Scholar] [CrossRef] [PubMed]
- Abbasi, M.S.; Bahrami, A.; Hosseini-Abari, A.S.; Saber, F.Y. Synthesis and characterization of composite coating of iron oxide and bioactive glass, coated by electrophoretic co-deposition method for biomedical applications. J. Adv. Mater. Eng. 2023, 42, 1–13. [Google Scholar]
- Hong, W.; Guo, F.; Chen, J.; Wang, X.; Zhao, X.; Xiao, P. Bioactive glass–chitosan composite coatings on PEEK: Effects of surface wettability and roughness on the interfacial fracture resistance and in vitro cell response. Appl. Surf. Sci. 2018, 440, 514–523. [Google Scholar] [CrossRef]
- Sanguedolce, M.; Rotella, G.; Curcio, F.; Pelaccia, R.; Siciliani, V.; Cassano, R.; Orazi, L.; Filice, L. Effects of Ti6Al4V mechanical and thermal surface modification on the adhesion of a chitosan-bioactive glass coating. Int. J. Adv. Manuf. Technol. 2023, 125, 4621–4629. [Google Scholar] [CrossRef]
- Przykaza, K.; Jurak, M.; Kalisz, G.; Mroczka, R.; Wiącek, A.E. Characteristics of Hybrid Bioglass-Chitosan Coatings on the Plasma Activated PEEK Polymer. Molecules 2023, 28, 1729. [Google Scholar] [CrossRef] [PubMed]
- Muñoz-Tebar, N.; Pérez-Álvarez, J.A.; Fernández-López, J.; Viuda-Martos, M. Chitosan Edible Films and Coatings with Added Bioactive Compounds: Antibacterial and Antioxidant Properties and Their Application to Food Products: A Review. Polymers 2023, 15, 396. [Google Scholar] [CrossRef]
- Gritsch, L.; Lovell, C.; Goldmann, W.H.; Boccaccini, A.R. Fabrication and characterization of copper(II)-chitosan complexes as antibiotic-free antibacterial biomaterial. Carbohydr. Polym. 2018, 179, 370–378. [Google Scholar] [CrossRef] [PubMed]
- El-Kattan, N.; Ibrahim, M.A.; Emam, A.N.; Metwally, K.; Youssef, F.S.; Nassar, N.A.; Mansour, A.S. Evaluation of the antimicrobial activity of chitosan- and curcumin-capped copper oxide nanostructures against multi-drug-resistant microorganisms. Nanoscale Adv. 2025, 7, 2988–3007. [Google Scholar] [CrossRef]
- Harding, J.L.; Krebs, M.D. Bioinspired Deposition-Conversion Synthesis of Tunable Calcium Phosphate Coatings on Polymeric Hydrogels. ACS Biomater. Sci. Eng. 2017, 3, 2024–2032. [Google Scholar] [CrossRef]
- Jeong, J.; Kim, J.H.; Shim, J.H.; Hwang, N.S.; Heo, C.Y. Bioactive calcium phosphate materials and applications in bone regeneration. Biomater. Res. 2019, 23, 4. [Google Scholar] [CrossRef] [PubMed]
- Jaita, P.; Chokethawai, K.; Randorn, C.; Boonsri, K.; Pringproa, K.; Thongkorn, K.; Watcharapasorn, A.; Jarupoom, P. Enhancing bioactivity and mechanical performances of hydroxyapatite–calcium sulfate bone cements for bone repair: In vivo histological evaluation in rabbit femurs. RSC Adv. 2024, 14, 23286–23302. [Google Scholar] [CrossRef] [PubMed]
- Skliarenko, Y.; Kolomiiets, V.V.; Balatskyi, V.V.; Galuza, Y.; Koryak, O.S.; Macewicz, L.L.; Ruban, T.P.; Firstov, S.A.; Ulianchych, N.V.; Piven, O.O. The impact of the physicochemical properties of calcium phosphate ceramics on biocompatibility and osteogenic differentiation of mesenchymal stem cells. BMC Res. Notes 2024, 17, 295. [Google Scholar] [CrossRef]
- Ai, F.; Chen, L.; Yan, J.; Yang, K.; Li, S.; Duan, H.; Cao, C.; Li, W.; Zhou, K. Hydroxyapatite scaffolds containing copper for bone tissue engineering. J. Sol-Gel Sci. Technol. 2020, 95, 168–179. [Google Scholar] [CrossRef]
- Kubiak-Mihkelsoo, Z.; Kostrzębska, A.; Błaszczyszyn, A.; Pitułaj, A.; Dominiak, M.; Gedrange, T.; Nawrot-Hadzik, I.; Matys, J.; Hadzik, J. Ionic Doping of Hydroxyapatite for Bone Regeneration: Advances in Structure and Properties over Two Decades—A Narrative Review. Appl. Sci. 2025, 15, 1108. [Google Scholar] [CrossRef]
- Gritsch, L.; Maqbool, M.; Mouriño, V.; Ciraldo, F.E.; Cresswell, M.; Jackson, P.R.; Lovell, C.; Boccaccini, A.R. Chitosan/hydroxyapatite composite bone tissue engineering scaffolds with dual and decoupled therapeutic ion delivery: Copper and strontium. J. Mater. Chem. B 2019, 7, 6109–6124. [Google Scholar] [CrossRef]

| Number | Time | Voltage |
|---|---|---|
| 1 | 5 min | 15 V |
| 2 | 10 min | 15 V |
| 3 | 15 min | 15 V |
| 4 | 20 min | 15 V |
| 5 | 5 min | 20 V |
| 6 | 10 min | 20 V |
| 7 | 15 min | 20 V |
| 8 | 20 min | 20 V |
| Classification | %Area Removed |
|---|---|
| 5B | 0% (NONE) |
| 4B | LESS THAN 5% |
| 3B | 5–15% |
| 2B | 15–35% |
| 1B | 35–65% |
| 0B | GREATER THAN 65% |
| Bacterial Growth Variation Relative to the Control Group, Expressed in Colony Forming (CFU/mL) | ||||
|---|---|---|---|---|
| Bacterial strain | Samples | Number of colonies (R × 105) | Number of colonies (R × 106) | Dilution (10−8) |
| Staphylococcus | 5CB | 0 | 0 | ↓(21.2–42.5) × 108 |
| Control sample | 425 | 85 | - | |
| Escherichia coli | 5CB | 0 | 0 | ↓(10.1–22.5) × 108 |
| Control sample | 203 | 45 | - | |
| Sample—Concentrations | 100 (µM) | 75 (µM) | 50 (µM) | 25 (µM) | 10 (µM) |
|---|---|---|---|---|---|
| AISI 316L | 77 | 75 (±10%) | 80 (±7%) | 78 (±5%) | 75 |
| Chit-5CB | 83 | 85 (±7%) | 87 (±5%) | 83 (±10%) | 81 |
| Control Sample | 100 | 100 | 100 | 100 | 100 |
| Calcium (Ca) mg/dL | Phosphorus (P) mg/dL | |
|---|---|---|
| SBF | 47.2 | 36.1 |
| The first week | 17.6 | 4.5 |
| The second week | 9.5 | 2.8 |
| The third week | 8.6 | 1.6 |
| The fourth week | 11.4 | 2.14 |
Disclaimer/Publisher’s Note: The statements, opinions and data contained in all publications are solely those of the individual author(s) and contributor(s) and not of MDPI and/or the editor(s). MDPI and/or the editor(s) disclaim responsibility for any injury to people or property resulting from any ideas, methods, instructions or products referred to in the content. |
© 2025 by the authors. Licensee MDPI, Basel, Switzerland. This article is an open access article distributed under the terms and conditions of the Creative Commons Attribution (CC BY) license (https://creativecommons.org/licenses/by/4.0/).
Share and Cite
Mahmoudabadi, S.M.R.; Bahrami, A.; Abbasi, M.S.; Rajabinezhad, M.; Fadaei Ardestani, B.; Heidari Laybidi, F. Electrophoretic Co-Deposition of Chitosan and Cu-Doped Bioactive Glass 45S5 Composite Coatings on AISI 316L Stainless Steel Substrate for Biomedical Applications. Crystals 2025, 15, 549. https://doi.org/10.3390/cryst15060549
Mahmoudabadi SMR, Bahrami A, Abbasi MS, Rajabinezhad M, Fadaei Ardestani B, Heidari Laybidi F. Electrophoretic Co-Deposition of Chitosan and Cu-Doped Bioactive Glass 45S5 Composite Coatings on AISI 316L Stainless Steel Substrate for Biomedical Applications. Crystals. 2025; 15(6):549. https://doi.org/10.3390/cryst15060549
Chicago/Turabian StyleMahmoudabadi, Sayed Mohammad Reza, Abbas Bahrami, Mohammad Saeid Abbasi, Mojtaba Rajabinezhad, Benyamin Fadaei Ardestani, and Farnaz Heidari Laybidi. 2025. "Electrophoretic Co-Deposition of Chitosan and Cu-Doped Bioactive Glass 45S5 Composite Coatings on AISI 316L Stainless Steel Substrate for Biomedical Applications" Crystals 15, no. 6: 549. https://doi.org/10.3390/cryst15060549
APA StyleMahmoudabadi, S. M. R., Bahrami, A., Abbasi, M. S., Rajabinezhad, M., Fadaei Ardestani, B., & Heidari Laybidi, F. (2025). Electrophoretic Co-Deposition of Chitosan and Cu-Doped Bioactive Glass 45S5 Composite Coatings on AISI 316L Stainless Steel Substrate for Biomedical Applications. Crystals, 15(6), 549. https://doi.org/10.3390/cryst15060549

